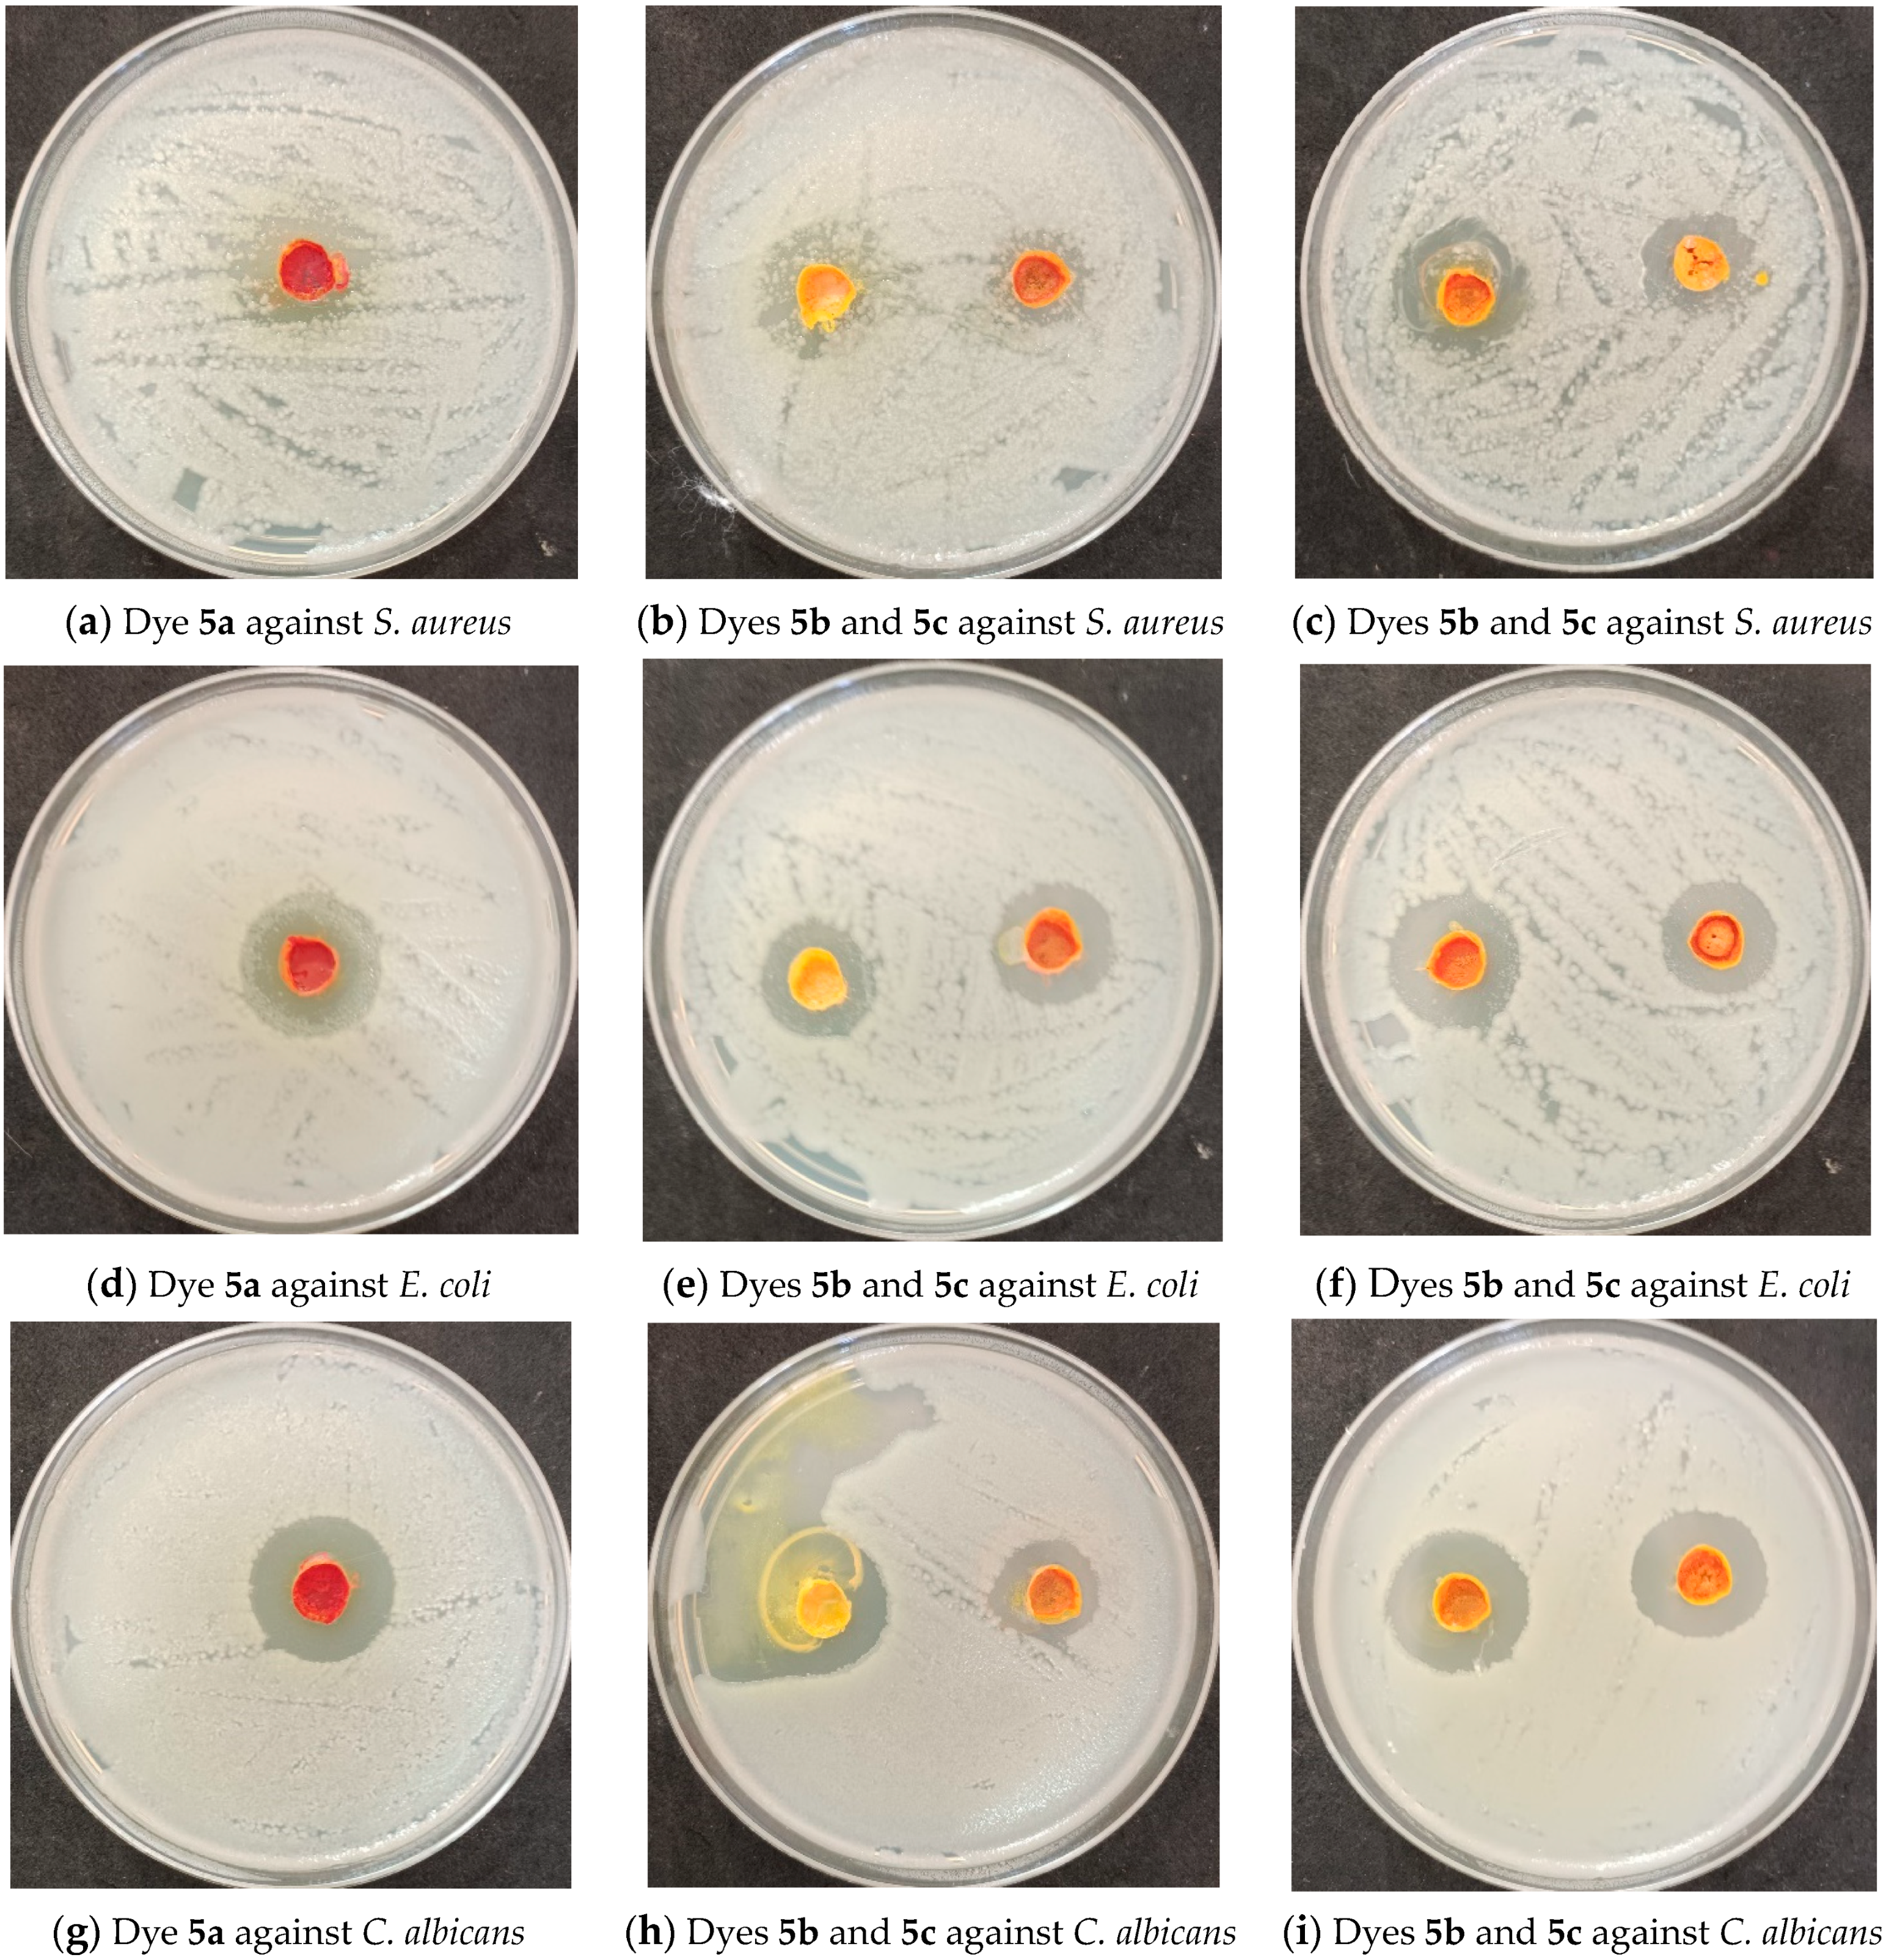
Molecules 29 02227 g005

Novel Disperse Dyes Based on Enaminones: Synthesis, Dyeing Performance on Polyester Fabrics, and Potential Biological Activities
Abstract
1. Introduction
2. Results and Discussions
2.1. Chemistry
2.2. Dye Uptake
2.3. Fastness Properties
2.4. Dyebath Reuse
2.5. Antimicrobial Activity
2.6. In Vitro Cytotoxicity Evaluation
2.7. In Vitro Cytotoxic Activity toward Normal Human WI-38
2.8. Antioxidant Activity
3. Materials and Methods
3.1. Preparation of 1-(3-Aryl)-3-(dimethylamino)prop-2-en-1-ones 3a–e
3.2. Synthesis of Dyes
3.3. Dyeing Procedure
3.4. Fastness Properties Tests
3.4.1. Light Fastness
3.4.2. Washing Fastness
3.5. Color Strength
3.6. Evaluation of the Biological Activities of the Disperse Dyes
4. Conclusions
Author Contributions
Funding
Institutional Review Board Statement
Informed Consent Statement
Data Availability Statement
Acknowledgments
Conflicts of Interest
References
- Abdelmoteleb, K.M.A.; El-Apasery, M.A.; Wasfy, A.A.F.; Ahmed, S.M. Synthesis of New Monoazo Disperse Dyes for Dyeing Polyester Fabric Using Two Different Dyeing Methods: Demonstration of Their Antibacterial and Anticancer Activities. Polymers 2023, 15, 3052. [Google Scholar] [CrossRef] [PubMed]
- Al-Awadi, N.A.; Ibrahim, M.R.; Abdelhamid, I.A.; Elnagdi, M.H. Arylhydrazonals as the aldehyde component in Baylis–Hillman reactions. Tetrahedron 2008, 64, 8202–8205. [Google Scholar] [CrossRef]
- A Al-Awadi, N.; Elnagdi, M.H.; A Ibrahim, Y.; Kaul, K.; Kumar, A. Efficient synthesis of 3-aroylcinnolines from aryl methyl ketones. Tetrahedron 2001, 57, 1609–1614. [Google Scholar] [CrossRef]
- Abdelrahman, M.A.; Salama, I.; Gomaa, M.S.; Elaasser, M.M.; Abdel-Aziz, M.M.; Soliman, D.H. Design, synthesis and 2D QSAR study of novel pyridine and quinolone hydrazone derivatives as potential antimicrobial and antitubercular agents. Eur. J. Med. Chem. 2017, 138, 698–714. [Google Scholar] [CrossRef]
- Kascheres, C.M. The chemistry of enaminones and small rings: Our contribution. J. Braz. Chem. Soc. 2003, 14, 945–969. [Google Scholar] [CrossRef]
- Pieczonka, A.M.; Strzelczyk, A.; Sadowska, B.; Mlostoń, G.; Stączek, P. Synthesis and evaluation of antimicrobial activity of hydrazones derived from 3-oxido-1H-imidazole-4-carbohydrazides. Eur. J. Med. Chem. 2013, 64, 389–395. [Google Scholar] [CrossRef] [PubMed]
- Shawali, A.S. Synthesis, Reactions and Antitumour Screening of new Enaminones. J. Chem. Res. 2010, 34, 630–634. [Google Scholar] [CrossRef]
- Šimůnek, P.; Macháček, V. The structure and tautomerism of azo coupled β-Enaminones. Dye. Pigment. 2010, 86, 197–205. [Google Scholar] [CrossRef]
- Al-Etaibi, A.M.; El-Apasery, M.A. Nano TiO2 Imparting Multifunctional Performance on Dyed Polyester Fabrics with some Disperse Dyes Using High Temperature Dyeing as an Environmentally Benign Method. Int. J. Environ. Res. Public Health 2020, 17, 1377. [Google Scholar] [CrossRef] [PubMed]
- Kumar, P.; Narasimhan, B. Hydrazides/Hydrazones as Antimicrobial and Anticancer Agents in the New Millennium. Mini-Rev. Med. Chem. 2013, 13, 971–987. [Google Scholar] [CrossRef]
- De Moraes, T.A.P.; Filha, M.J.S.; Camara, C.A.; Silva, T.M.S.; Soares, B.M.; Bomfim, I.S.; Pessoa, C.; Ximenes, G.C.; Silva, V.A. Synthesis and Cytotoxic Evaluation of a Series of 2-Amino-Naphthoquinones against Human Cancer Cells. Molecules 2014, 19, 13188–13199. [Google Scholar] [CrossRef] [PubMed]
- Wang, Z.; Xue, M.; Huang, K.; Liu, Z. Textile dyeing wastewater treatment. Adv. Treat. Text. Effl. 2011, 5, 91–116. [Google Scholar]
- Bhatt, P.; Rani, A. Textile dyeing and printing industry: An environmental hazard. Asian Dye. 2013, 10, 51–54. [Google Scholar]
- Holkar, C.R.; Jadhav, A.J.; Pinjari, D.V.; Mahamuni, N.M.; Pandit, A.B. A critical review on textile wastewater treatments: Possible approaches. J. Environ. Manag. 2016, 182, 351–366. [Google Scholar] [CrossRef]
- Rodrigues, C.S.; Madeira, L.M.; Boaventura, R.A. Synthetic textile dyeing wastewater treatment by integration of advanced oxidation and biological processes—Performance analysis with costs reduction. J. Environ. Chem. Eng. 2014, 2, 1027–1039. [Google Scholar] [CrossRef]
- Vergili, I.; Kaya, Y.; Sen, U.; Gönder, Z.B.; Aydiner, C. Techno-economic analysis of textile dye bath wastewater treatment by integrated membrane processes under the zero liquid discharge approach. Resour. Conserv. Recycl. 2012, 58, 25–35. [Google Scholar] [CrossRef]
- Starling, M.C.V.M.; Castro, L.A.S.; Marcelino, R.B.P.; Leão, M.M.D.; Amorim, C.C. Optimized treatment conditions for textile wastewater reuse using photocatalytic processes under UV and visible light sources. Environ. Sci. Pollut. Res. 2016, 24, 6222–6232. [Google Scholar] [CrossRef] [PubMed]
- Kaur, P.; Sangal, V.K.; Kushwaha, J.P. Parametric study of electro-fenton treatment for real textile wastewater, disposal study and its cost analysis. Int. J. Environ. Sci. Technol. 2019, 16, 801–810. [Google Scholar] [CrossRef]
- Kobya, M.; Gengec, E.; Demirbas, E. Operating parameters and costs assessments of a real dye house wastewater effluent treated by a continuous electrocoagulation process. Chem. Eng. Process. Process Intensif. 2016, 101, 87–100. [Google Scholar] [CrossRef]
- Metwally, K.A.; Abdel-Aziz, L.M.; Lashine, E.-S.M.; Husseiny, M.I.; Badawy, R.H. Hydrazones of 2-aryl-quinoline-4-carboxylic acid hydrazides: Synthesis and preliminary evaluation as antimicrobial agents. Bioorganic Med. Chem. 2006, 14, 8675–8682. [Google Scholar] [CrossRef] [PubMed]
- Rehman, F.U.; Adeel, S.; Saif, M.J.; Khosa, M.K.; Anjum, M.N.; Kamran, M.; Zuber, M.; Asif, M. Ultrasonic Assisted Improvement in Dyeing Behaviour of Polyester Fabric Using Disperse Red 343. Pol. J. Environ. Stud. 2019, 29, 261–265. [Google Scholar] [CrossRef] [PubMed]
- Lozada, M.C.; Soria-Arteche, O.; Apan, M.T.R.; Nieto-Camacho, A.; Enríquez, R.G.; Izquierdo, T.; Jiménez-Corona, A. Synthesis, cytotoxic and antioxidant evaluations of amino derivatives from perezone. Bioorganic Med. Chem. 2012, 20, 5077–5084. [Google Scholar] [CrossRef]
- Sriram, D.; Yogeeswari, P.; Madhu, K. Synthesis and in vitro and in vivo antimycobacterial activity of isonicotinoyl hydrazones. Bioorganic Med. Chem. Lett. 2005, 15, 4502–4505. [Google Scholar] [CrossRef] [PubMed]
- Stefanidis, G.D.; Muñoz, A.N.; Sturm, G.S.; Stankiewicz, A. A helicopter view of microwave application to chemical processes: Reactions, separations, and equipment concepts. Rev. Chem. Eng. 2014, 30, 233–259. [Google Scholar] [CrossRef]
- El-Apasery, M.A.; Abdellatif, M.E.A.; Yassin, F.A.; Ahmed, S.M. Synthesis of novel disperse dyes based on arylazophenols: Synthesis, Characterizations and applications. Bull. Chem. Soc. Ethiop. 2023, 37, 993–1002. [Google Scholar] [CrossRef]
- Iskender, M.A.; Becerir, B.; Koruyucu, A. Carrier Dyeing of Different Energy Level Disperse Dyes on Polyester Fabric. Text. Res. J. 2005, 75, 462–465. [Google Scholar] [CrossRef]
- Alnajjar, A.; Abdelkhalik, M.M.; Al-Enezi, A.; Elnagdi, M.H. Enaminones as building blocks in heterocyclic syntheses: Reinves-tigating the product structures of enaminones with malononitrile. A novel route to 6-substituted-3-oxo-2,3- dihydro-pyridazine-4-carboxylic acids. Molecules 2009, 14, 68–77. [Google Scholar] [CrossRef] [PubMed]
- Al-Etaibi, A.M.; El-Apasery, M.A. Can Novel Synthetic Disperse Dyes for Polyester Fabric Dyeing Provide Added Value? Polymers 2023, 15, 1845. [Google Scholar] [CrossRef]
- Delgado, V.; Ibacache, A.; Theoduloz, C.; Valderrama, J.A. Synthesis and in Vitro Cytotoxic Evaluation of Aminoquinones Structurally Related to Marine Isoquinolinequinones. Molecules 2012, 17, 7042–7056. [Google Scholar] [CrossRef]
- El-Apasery, M.A.; Abdellatif, M.; Yassin, F.; Ahmed, S.M. Synthesis of Novel Disperse Dyes based on Arylazophenols: Part 2. Anticancer Activities. Egypt. J. Chem. 2023, 66, 49–53. [Google Scholar] [CrossRef]
- El-Apasery, M.A.; Abdellatif, M.E.A.; Ahmed, S.M. Synthesis of Novel Disperse Dyes based on Arylazophenols: Part 3.High Temperature Dyeing of Polyester Fabrics. Egypt. J. Chem. 2023, 66, 21–25. [Google Scholar] [CrossRef]
- Sehim, A.E.; Amin, B.H.; Yosri, M.; Salama, H.M.; Alkhalifah, D.H.; Alwaili, M.A.; Abd Elghaffar, R.Y. GC-MS Analysis, Antibacterial, and Anticancer Activities of Hibiscus sabdariffa L. Methanolic Extract: In Vitro and In Silico Studies. Microorganisms 2023, 11, 1601. [Google Scholar] [CrossRef] [PubMed]
- Sarker, S.D.; Nahar, L.; Kumarasamy, Y. Microliter plate-based antibacterial assay incorporating resazurin as an indicator of cell growth, and its application in the in vitro antibacterial screening of phytochemicals. Methods 2007, 42, 321–324. [Google Scholar] [CrossRef]
- Valderrama, J.A.; Delgado, V.; Sepúlveda, S.; Benites, J.; Theoduloz, C.; Calderon, P.B.; Muccioli, G.G. Synthesis and Cytotoxic Activity on Human Cancer Cells of Novel Isoquinolinequinone–Amino Acid Derivatives. Molecules 2016, 21, 1199. [Google Scholar] [CrossRef] [PubMed]
- Badisa, R.B.; Darling-Reed, S.F.; Joseph, P.; Cooperwood, J.S.; Latinwo, L.M.; Goodman, C.B. Selective cytotoxic activities of two novel synthetic drugs on human breast carcinoma MCF-7 cells. Anticancer Res. 2009, 29, 2993–2996. [Google Scholar]
- Mosmann, T. Rapid colorimetric assay for cellular growth and survival: Application to proliferation and cytotoxicity assays. J. Immunol. Methods 1983, 65, 55–63. [Google Scholar] [CrossRef]
- Abo-Ashour, M.F.; Eldehna, W.M.; Nocentini, A.; Bonardi, A.; Bua, S.; Ibrahim, H.S.; Elaasser, M.M.; Kryštof, V.; Jorda, R.; Gratteri, P.; et al. 3-Hydrazinoisatin-based benzenesulfonamides as novel carbonic anhydrase inhibitors endowed with anticancer activity: Synthesis, in vitro biological evaluation and in silico insights. Eur. J. Med. Chem. 2019, 184, 111768. [Google Scholar] [CrossRef] [PubMed]
- Balouiri, M.; Sadiki, M.; Ibnsouda, S.K. Methods for in vitro evaluating antimicrobial activity: A review. J. Pharm. Anal. 2015, 6, 71–79. [Google Scholar] [CrossRef]
- Elassar, A.-Z.A.; Al-Mousawi, S.M.; Helal, M.H.; Elgazzar, M.E. Synthesis of N-substituted arylhydrazones: Applying to polyester fabric as disperse dyes. Pigment. Resin Technol. 2017, 46, 449–457. [Google Scholar] [CrossRef]

| Dye No | Name | Yield | I.R. (cm−1) | λmax in DMSO * | MS m/z | 1H NMR | Elemental Analysis |
|---|---|---|---|---|---|---|---|
| 5a | (E)-2-(2-(4-chlorophenyl)hydrazono)-3-oxo-3- phenylpropanal | 77% | 3435, 3160, 1648, 1589 | 383 | (M − 1)+ = 385.59 | (CDCl3): δ 7.24–7.95 (m, 9H, arom-H) 10.18 (s, 1H, CHO), 14.55 (s, 1H, NH). | C15H11ClN2O2, Calcd: C, 62.84; H, 3.87; N, 9.77. Found: C, 62.81; H, 3.84; N, 9.84 |
| 5b | (E)-2-(2-(4-chlorophenyl)hydrazono)-3-(3-methoxyphenyl)-3-oxopropanal | 80% | 3431, 3100, 1640, 1589 | 380.5 | (M − 1)+ = 315.44 | (CDCl3): δ 3.86 (s, 3H, OCH3), 7.12–7.53 (m, 8H, arom-H) 10.16 (s, 1H, CHO), 14.67 (s, 1H, NH). | C16H13ClN2O3, Calcd: C, 60.67; H, 4.14; N, 8.84. Found: C, 60.41; H, 4.19; N, 8.92. |
| 5c | (E)-3-(3-chlorophenyl)-2-(2-(4-chlorophenyl)hydrazono)-3-oxopropanal | 71% | 3431, 2979, 1645, 1568 | 382.5 | (M − 2)+ = 319.73 | (CDCl3): δ 7.27–8.92 (m, 8H, arom-H), 10.18 (s, 1H, CHO), 14.71 (s, 1H, NH). | C15H10Cl2N2O2, Calcd: C, 56.10; H, 3.14; N, 8.72. Found: C, 56.21; H, 3.05; N, 8.66. |
| 5d | (E)-3-(3-bromophenyl)-2-(2-(4-chlorophenyl)hydrazono)-3-oxopropanal | 73% | 3432, 2919, 1646, 1522 | 383.5 | (M)+ = 365.19 | (CDCl3): δ 7.26–8.11 (m, 8H, arom-H), 10.17 (s, 1H, CHO), 14.70 (s, 1H, NH). | C15H10BrClN2O2,Calcd: C, 49.28; H, 2.76; N, 7.66. Found: C, 49.32; H, 2.73; N, 7.71. |
| 5e | (E)-2-(2-(4-chlorophenyl)hydrazono)-3-(3-nitrophenyl)-3-oxopropanal | 84% | 3431, 2918, 1644, 1579 | 381 | (M − 1)+ = 330.77 | (CDCl3): δ 7.27–8.96 (m, 8H, arom-H), 10.23 (s, 1H, CHO), 14.83 (s, 1H, NH). | C15H10ClN3O4, Calcd: C, 54.31; H, 3.04; N, 12.67. Found: C, 54.23; H, 3.11; N, 12.62 |
| Dye No. | K/S | λmax | L* | C* | a* | h* | b* |
|---|---|---|---|---|---|---|---|
| 5a | 15.51 | 380 | 71.68 | 68.55 | 4.89 | 85.91 | 68.37 |
| 5b | 14.33 | 380 | 72.01 | 67.51 | 1.54 | 88.69 | 67.49 |
| 5c | 11.97 | 380 | 74.01 | 70.08 | 0.24 | 89.80 | 70.08 |
| 5d | 14.31 | 380 | 74.58 | 63.14 | −3.86 | 93.51 | 63.02 |
| 5e | 12.14 | 380 | 73.00 | 67.36 | 1.69 | 88.56 | 67.33 |
| Dye No. | K/S | λmax | L* | C* | a* | h* | b* |
|---|---|---|---|---|---|---|---|
| 5a | 14.62 | 380 | 65.75 | 67.78 | 14.88 | 77.32 | 66.13 |
| 5b | 14.00 | 380 | 71.82 | 65.97 | 2.33 | 87.98 | 65.93 |
| 5c | 12.75 | 380 | 74.73 | 65.10 | −2.76 | 92.43 | 65.04 |
| 5d | 11.98 | 380 | 73.96 | 68.73 | 0.21 | 89.83 | 68.73 |
| 5e | 11.38 | 380 | 72.96 | 63.53 | 0.00 | 90.00 | 63.53 |
| Dye No | Light Fastness | Rubbing Fastness | Washing Fastness | Perspiration Fastness | |||||||||||
|---|---|---|---|---|---|---|---|---|---|---|---|---|---|---|---|
| Acid | Alkaline | ||||||||||||||
| Dry | Wet | St. | St. * | St. ** | Alt. | St. | St. * | St. ** | Alt. | St. | St. * | St. ** | Alt. | ||
| 5a | 3–4 | 3–4 | 3–4 | 4 | 4 | 4 | 4 | 4–5 | 4–5 | 4–5 | 4 | 4–5 | 4–5 | 4–5 | 4 |
| 5b | 4 | 4 | 4 | 4 | 4 | 4 | 4 | 4–5 | 4–5 | 4–5 | 4 | 4–5 | 4–5 | 4–5 | 4 |
| 5c | 4 | 4 | 3–4 | 4 | 4 | 4 | 4 | 4–5 | 4–5 | 4–5 | 4 | 4–5 | 4–5 | 4–5 | 4 |
| 5d | 3–4 | 4 | 4 | 4 | 4 | 4 | 4 | 4–5 | 4–5 | 4–5 | 4 | 4–5 | 4–5 | 4–5 | 4 |
| 5e | 3–4 | 3–4 | 3–4 | 4 | 4 | 4 | 4 | 4–5 | 4–5 | 4–5 | 4 | 4–5 | 4–5 | 4–5 | 4 |
| Dye No | Light Fastness | Rubbing Fastness | Washing Fastness | Perspiration Fastness | |||||||||||
|---|---|---|---|---|---|---|---|---|---|---|---|---|---|---|---|
| Acid | Alkaline | ||||||||||||||
| Dry | Wet | St. | St. * | St. ** | Alt. | St. | St. * | St. ** | Alt. | St. | St. * | St. ** | Alt. | ||
| 5a | 4–5 | 3–4 | 3–4 | 4 | 4 | 4 | 4 | 4–5 | 4–5 | 4–5 | 4 | 4–5 | 4–5 | 4–5 | 4 |
| 5b | 4 | 3–4 | 3–4 | 4 | 4 | 4 | 4 | 4–5 | 4–5 | 4–5 | 4 | 4–5 | 4–5 | 4–5 | 4 |
| 5c | 4 | 3–4 | 3–4 | 4 | 4 | 4 | 4 | 4–5 | 4–5 | 4–5 | 4 | 4–5 | 4–5 | 4–5 | 4 |
| 5d | 4 | 3–4 | 3–4 | 4 | 4 | 4 | 4 | 4–5 | 4–5 | 4–5 | 4 | 4–5 | 4–5 | 4–5 | 4 |
| 5e | 4 | 3–4 | 3–4 | 4 | 4 | 4 | 4 | 4–5 | 4–5 | 4–5 | 4 | 4–5 | 4–5 | 4–5 | 4 |
| Dye No. | Dyeing Procedure * | K/S | λmax | L* | C* | a* | h* | b* |
|---|---|---|---|---|---|---|---|---|
| 5a | Dyebath reuse A | 0.50 | 380 | 81.05 | 6.54 | −2.86 | 115.98 | 5.88 |
| Dyebath reuse B | 0.24 | 380 | 81.66 | 1.45 | −1.01 | 133.81 | 1.05 | |
| 5b | Dyebath reuse A | 0.39 | 380 | 81.39 | 5.48 | −2.70 | 119.57 | 4.77 |
| Dyebath reuse B | 0.21 | 380 | 81.16 | 0.85 | −0.65 | 139.73 | 0.55 | |
| 5c | Dyebath reuse A | 0.70 | 380 | 81.04 | 11.10 | −4.79 | 115.56 | 10.01 |
| Dyebath reuse B | 0.21 | 380 | 81.45 | 0.88 | −0.78 | 153.16 | 0.40 | |
| 5d | Dyebath reuse A | 0.71 | 380 | 81.91 | 11.82 | −4.76 | 113.76 | 10.82 |
| Dyebath reuse B | 0.23 | 380 | 81.94 | 1.71 | −0.90 | 121.87 | 1.46 | |
| 5e | Dyebath reuse A | 0.40 | 380 | 81.81 | 6.07 | −2.46 | 113.94 | 5.55 |
| Dyebath reuse B | 0.22 | 380 | 81.50 | 0.90 | −0.71 | 142.01 | 0.56 |
| Dye No. | Dyeing Procedure | K/S | λmax | L* | C* | a* | h* | b* |
|---|---|---|---|---|---|---|---|---|
| 5a | Dyebath reuse A | 4.34 | 380 | 78.47 | 39.29 | −8.82 | 102.98 | 38.28 |
| Dyebath reuse B | 0.46 | 380 | 80.26 | 5.86 | −2.86 | 119.24 | 5.11 | |
| 5b | Dyebath reuse A | 3.83 | 380 | 79.25 | 36.62 | −9.92 | 105.72 | 35.25 |
| Dyebath reuse B | 0.67 | 380 | 80.19 | 10.31 | −4.63 | 116.65 | 9.22 | |
| 5c | Dyebath reuse A | 1.47 | 380 | 80.08 | 22.42 | −8.01 | 110.94 | 20.94 |
| Dyebath reuse B | 0.30 | 380 | 80.11 | 2.68 | −1.97 | 137.24 | 1.82 | |
| 5d | Dyebath reuse A | 1.39 | 380 | 80.05 | 22.16 | −7.19 | 108.92 | 20.96 |
| Dyebath reuse B | 0.47 | 380 | 79.65 | 5.91 | −2.36 | 113.51 | 5.42 | |
| 5e | Dyebath reuse A | 1.20 | 380 | 80.06 | 21.00 | −7.67 | 111.43 | 19.55 |
| Dyebath reuse B | 0.23 | 380 | 79.79 | 0.90 | −0.89 | 189.73 | −0.15 |
| Dye No. | Dyeing Procedure | Rubbing Fastness | Washing Fastness | Perspiration Fastness | |||||||||||
|---|---|---|---|---|---|---|---|---|---|---|---|---|---|---|---|
| Acid | Alkaline | ||||||||||||||
| Dry | Wet | St. | St. * | St. ** | Alt. | St. | St. * | St. ** | Alt. | St. | St. * | St. ** | Alt. | ||
| 5a | Dye bath reuse A | 4–5 | 4 | 4 | 4 | 4 | 4 | 4–5 | 4–5 | 4–5 | 4 | 4–5 | 4–5 | 4–5 | 4 |
| Dye bath reuse B | 4 | 4 | 4 | 4 | 4 | 4 | 4–5 | 4–5 | 4–5 | 4 | 4–5 | 4–5 | 4–5 | 4 | |
| 5b | Dye bath reuse A | 3–4 | 3–4 | 4 | 4 | 4 | 4 | 4–5 | 4–5 | 4–5 | 4 | 4–5 | 4–5 | 4–5 | 4 |
| Dye bath reuse B | 3–4 | 4 | 4 | 4 | 4 | 4 | 4–5 | 4–5 | 4–5 | 4 | 4–5 | 4–5 | 4–5 | 4 | |
| 5c | Dye bath reuse A | 4 | 4 | 4 | 4 | 4 | 4 | 4–5 | 4–5 | 4–5 | 4 | 4–5 | 4–5 | 4–5 | 4 |
| Dye bath reuse B | 3–4 | 4 | 4 | 4 | 4 | 4 | 4–5 | 4–5 | 4–5 | 4 | 4–5 | 4–5 | 4–5 | 4 | |
| 5d | Dye bath reuse A | 4 | 4 | 4 | 4 | 4 | 4 | 4–5 | 4–5 | 4–5 | 4 | 4–5 | 4–5 | 4–5 | 4 |
| Dye bath reuse B | 4 | 4 | 4 | 4 | 4 | 4 | 4–5 | 4–5 | 4–5 | 4 | 4–5 | 4–5 | 4–5 | 4 | |
| 5e | Dye bath reuse A | 4–5 | 4 | 4 | 4 | 4 | 4 | 4–5 | 4–5 | 4–5 | 4 | 4–5 | 4–5 | 4–5 | 4 |
| Dye bath reuse B | 3–4 | 4 | 4 | 4 | 4 | 4 | 4–5 | 4–5 | 4–5 | 4 | 4–5 | 4–5 | 4–5 | 4 | |
| Dye No | Dyeing Procedure | Rubbing Fastness | Washing Fastness | Perspiration Fastness | |||||||||||
|---|---|---|---|---|---|---|---|---|---|---|---|---|---|---|---|
| Acid | Alkaline | ||||||||||||||
| Dry | Wet | St. | St. * | St. ** | Alt. | St. | St. * | St. ** | Alt. | St. | St. * | St. ** | Alt. | ||
| 5a | Dye bath reuse A | 4 | 4 | 4 | 4 | 4 | 4 | 4–5 | 4–5 | 4–5 | 4 | 4–5 | 4–5 | 4–5 | 4 |
| Dye bath reuse B | 4–5 | 4 | 4 | 4 | 4 | 4 | 4–5 | 4–5 | 4–5 | 4 | 4–5 | 4–5 | 4–5 | 4 | |
| 5b | Dye bath reuse A | 3–4 | 4 | 4 | 4 | 4 | 4 | 4–5 | 4–5 | 4–5 | 4 | 4–5 | 4–5 | 4–5 | 4 |
| Dye bath reuse B | 4 | 4 | 4 | 4 | 4 | 4 | 4–5 | 4–5 | 4–5 | 4 | 4–5 | 4–5 | 4–5 | 4 | |
| 5c | Dye bath reuse A | 4 | 4 | 4 | 4 | 4 | 4 | 4–5 | 4–5 | 4–5 | 4 | 4–5 | 4–5 | 4–5 | 4 |
| Dye bath reuse B | 4–5 | 4 | 4 | 4 | 4 | 4 | 4–5 | 4–5 | 4–5 | 4 | 4–5 | 4–5 | 4–5 | 4 | |
| 5d | Dye bath reuse A | 4 | 4 | 4 | 4 | 4 | 4 | 4–5 | 4–5 | 4–5 | 4 | 4–5 | 4–5 | 4–5 | 4 |
| Dye bath reuse B | 4–5 | 4 | 4 | 4 | 4 | 4 | 4–5 | 4–5 | 4–5 | 4 | 4–5 | 4–5 | 4–5 | 4 | |
| 5e | Dye bath reuse A | 4 | 4 | 4 | 4 | 4 | 4 | 4–5 | 4–5 | 4–5 | 4 | 4–5 | 4–5 | 4–5 | 4 |
| Dye bath reuse B | 4–5 | 4 | 4 | 4 | 4 | 4 | 4–5 | 4–5 | 4–5 | 4 | 4–5 | 4–5 | 4–5 | 4 | |
| Dye No. | Inhibition Zone (mm) | |||
|---|---|---|---|---|
| Staphylococcus aureus | Escherichia coli | Candida albicans | Aspergillus niger | |
| 5a | 24 | 29 | 27 | 0 |
| 5b | 25 | 22 | 28 | 0 |
| 5c | 15 | 24 | 19 | 0 |
| 5d | 28 | 27 | 27 | 0 |
| 5e | 21 | 25 | 26 | 0 |
| Neomycin | 34 | 32 | 37 | 0 |
| Cyclohexamide | 0 | 0 | 0 | 35 |
| Dye No. | Cytotoxic Activity (IC50 µg/mL) | |||
|---|---|---|---|---|
| HepG-2 | A-549 | HCT-116 | MCF-7 | |
| 5a | 1.48 ± 0.08 | 2.91 ± 0.23 | 3.48 ± 0.14 | 1.99 ± 0.11 |
| 5b | 99.07 ± 2.88 | 50.60 ± 2.34 | 60.39 ± 1.29 | 27.10 ± 1.82 |
| 5c | 2.48 ± 0.09 | 5.03 ± 0.67 | 3.89 ± 0.18 | 3.39 ± 0.25 |
| 5d | 6.38 ± 0.54 | 13.67 ± 0.93 | 8.92 ± 0.87 | 10.03 ± 1.09 |
| 5e | 9.23 ± 0.78 | 24.60 ± 1.73 | 14.28 ± 0.98 | 21.76 ± 1.43 |
| Cisplatin | 3.69 ± 0.27 | 7.49 ± 0.65 | 2.54 ± 0.23 | 5.68 ± 0.44 |
| Dye No. | (CC50 µg/mL) Lung WI-38 | Selectivity Index | |||
|---|---|---|---|---|---|
| HepG-2 | A-549 | HCT-116 | MCF-7 | ||
| 5a | 21.23 ± 2.79 | 14.3 | 7.3 | 6.1 | 10.7 |
| 5b | 241.94 ± 11.34 | 2.4 | 4.8 | 4.0 | 8.9 |
| 5c | 55.60 ± 4.13 | 22.4 | 11.1 | 14.3 | 16.4 |
| 5d | 59.82 ± 4.65 | 9.4 | 4.4 | 6.7 | 6 |
| 5e | 56.91 ± 4.32 | 6.2 | 2.3 | 4 | 2.6 |
| Dye No. | Antioxidant Activity (IC50 µg/mL) |
|---|---|
| 5a | 40.99 ± 3.12 |
| 5b | 51.87 ± 3.29 |
| 5c | 195.75 ± 4.97 |
| 5d | 15.33 ± 0.61 |
| 5e | 60.18 ± 3.46 |
| Ascorbic acid | 10.62 ± 0.84 |
Disclaimer/Publisher’s Note: The statements, opinions and data contained in all publications are solely those of the individual author(s) and contributor(s) and not of MDPI and/or the editor(s). MDPI and/or the editor(s) disclaim responsibility for any injury to people or property resulting from any ideas, methods, instructions or products referred to in the content. |
© 2024 by the authors. Licensee MDPI, Basel, Switzerland. This article is an open access article distributed under the terms and conditions of the Creative Commons Attribution (CC BY) license (https://creativecommons.org/licenses/by/4.0/).
Share and Cite
Abdelmoteleb, K.M.A.; Wasfy, A.A.F.; El-Apasery, M.A. Novel Disperse Dyes Based on Enaminones: Synthesis, Dyeing Performance on Polyester Fabrics, and Potential Biological Activities. Molecules 2024, 29, 2227. https://doi.org/10.3390/molecules29102227
Abdelmoteleb KMA, Wasfy AAF, El-Apasery MA. Novel Disperse Dyes Based on Enaminones: Synthesis, Dyeing Performance on Polyester Fabrics, and Potential Biological Activities. Molecules. 2024; 29(10):2227. https://doi.org/10.3390/molecules29102227
Chicago/Turabian StyleAbdelmoteleb, Khaled M. A., Ashraf A. F. Wasfy, and Morsy Ahmed El-Apasery. 2024. "Novel Disperse Dyes Based on Enaminones: Synthesis, Dyeing Performance on Polyester Fabrics, and Potential Biological Activities" Molecules 29, no. 10: 2227. https://doi.org/10.3390/molecules29102227
APA StyleAbdelmoteleb, K. M. A., Wasfy, A. A. F., & El-Apasery, M. A. (2024). Novel Disperse Dyes Based on Enaminones: Synthesis, Dyeing Performance on Polyester Fabrics, and Potential Biological Activities. Molecules, 29(10), 2227. https://doi.org/10.3390/molecules29102227

